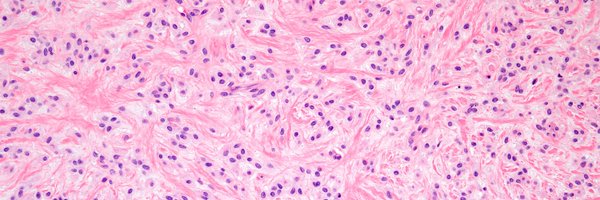

Emily Towery, MD
@EToweryMD
Followers
4K
Following
16K
Media
124
Statuses
12K
BST and gyn pathologist @BIDMCpath @harvardmed | ❤ 🔬 | path roots @BWHPath @UVA_Pathology | co-founder @Path_SIG | (formerly @pathnoob) she/her
Boston, MA
Joined October 2017
https://t.co/Ww4DWgQwKK: Angiomyolipomas (PEComa family) can affect the kidney, but are more likely to arise in the kidney and involve the adrenal gland secondarily. Classic angiomyolipomas are triphasic tumors consisting of perivascular epithelioid cells clustered around
1
15
46
More on infectious disease pathology ( https://t.co/FcZSxlmu8o): Disseminated disease occurs in 25-40% of patients with pulmonary blastomycosis (buzz words: "broad-based budding"), with the most frequent sites being skin, bone, GU tract, and CNS. H&E, GMS, and PAS shown. #IDpath
1
7
20
From the infectious disease fascicle ( https://t.co/FcZSxllWiQ): Giardia duodenalis is one of the most common intestinal parasites. On biopsy, small bowel mucosa may appear entirely normal with trophozoites in the intervillous spaces in a “falling leaves” pattern. #IDpath
0
7
23
One of my favorite 40x fields I've ever seen! Beautiful ladybird cells (neoplastic cells with a cytoplasmic rim of hemosiderin) in a tenosyonvial giant cell tumor. #BSTpath
2
28
123
More from the non-helminth infectious diseases fascicle ( https://t.co/FcZSxllWiQ): Leprosy, caused by Mycobacterium leprae/Mycobacterium lepromatosis, has diverse histologic findings; tuberculoid leprosy has perineural lymphocyte and epithelioid histiocyte infiltrates. #IDpath
1
6
22
More from the infectious disease fascicle ( https://t.co/FcZSxllWiQ): Rabies virus is a neurotropic, enveloped, nonsegmented, single-stranded RNA virus, and is uniformly fatal in humans once clinical symptoms start. In infected brain tissue, Negri bodies can be seen. #IDpath
2
9
15
⭐ MACROSCOPIC PATHOLOGY⭐ If you haven't read our March 2024 issue on Macroscopic Pathology https://t.co/gMEt7GAOde, here's another opportunity. Two-day seminar organized by Dr. Murali Varma. And it's free! Register now! @MuraliV72899596
0
16
28
This classic example of ossifying fibromyxoid tumor displays a shell of bone and uniform cytologic features; it's an H&E diagnosis. Without classic features, detecting PFH1 rearrangements (several partner genes reported) is useful. #UMiamiPath PMIDs: PMID: 2476942, 23887158.
3
31
93
2
8
46
Returning home from #ECP24 (which was fantastic) I hit the lottery: a row of 3 seats to myself on a transatlantic flight!
1
0
23
9 yo F. Back nodule. Clinical dx: lipoma vs cyst. WSI digital slides: https://t.co/fCiNctDuHf Stains: https://t.co/j2n8z6erPX Answer: https://t.co/wRvRRtvGK3
#pathology #pathologists #pathTwitter #dermpath #dermatology #dermatologia #dermtwitter #BSTpath
1
9
23
Carotid body paraganglioma with aberrant SDHB immunostaining. Patient with bilateral carotid body paragangliomas. SDHB immunostain shows significantly decreased expression in the lesional cells. Genetic testing revealed a pathogenic mutation in the SDHD gene. #pathtwitter
1
8
26
ERBB2/ ERBB3-mutated S100/ SOX10-positive unclassified high-grade uterine sarcoma: first detailed description of a novel entity
link.springer.com
Virchows Archiv - With the increasing use of innovative next generation sequencing (NGS) platforms in routine diagnostic and research settings, the genetic landscape of uterine sarcomas has been...
0
18
31
Tumors in the skin with the morphology of leiomyosarcoma (B-D) but that are confined to the dermis (no subcutis infiltration) are termed atypical intradermal smooth muscle tumors (AISMT). This distinction is made as AISMT can recur, but has no metastatic potential. #DermPath
2
19
57
30 F. Mass in lumen of femoral vein. Diagnosis? WSI digital slides: https://t.co/7EGBShOiOG Immunostains: https://t.co/E6Yrd12tRa Answer & Video: https://t.co/onzv86ecSn
#pathology #pathologists #pathTwitter #dermpath #dermatology #dermatologia #dermtwitter #BSTpath
3
5
31